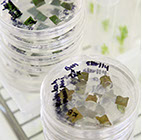
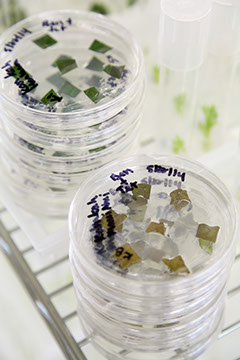

LYON ARBORETUM
ハワイの自然保護の拠点、ライアン植物園
第一次世界大戦のハワイは、戦時中に持ち込まれた牧畜用の牛によって広範囲が裸地化され、土地は荒廃してしまいました。1918年、ハワイのサトウキビ協会はその森林の回復プロジェクトのために、ミネソタ大学で植物病理学の学位を取得した若き植物学者ハロルド L.ライアン博士をプロジェクトの担当者として招きました。
ライアン博士はハワイの原風景を取り戻すべく、約2000主の草木種を124エーカーの荒廃した土地に植樹し、土と植物の研究を重ねること35年、現在のマノアバレーに置ける熱帯雨林の森林を取り戻すことに成功します。再生された森林はマノア植物園としてハワイの人々に愛されました。
このマノアバレーにおける森林再生プロジェクトの研究は、1953年ライアン博士の提案により、サトウキビ協会からハワイ州立ハワイ大学の研究機関として移管され、教育と公共奉仕のために使われることとなりました。ライアン博士が1957年に他界した時、政府の委員会は研究施設を新たに設立し、ほぼ40年にわたりこの森とハワイの自然を育てた博士を記念して、ハロルド L.ライアン アーボリータム(ライアン植物園)として名前を変えました。
ライアン植物園は植物園としてだけでなく、絶滅危惧植物として認定された300種以上のハワイ固有の原生植物の研究と保護、繁殖活動の拠点として貢献しています。
go to Lyon Arboretum
本当にハワイが好きだから。
どんな植物が絶滅の危機に瀕し、ハワイの固有種を絶滅から守るためにどんな活動がおこなわれているのか。私たちにできることはそれらを知り、伝え、ひとつでも多くの花の香りを未来の子どもたちに残すこと。現在FLOW with ALOHAプロジェクトを通してプカラニシリーズの売り上げの一部をLyon Arboretumの活動支援として寄付をさせていただいています。

pukalani brand curated by
ALOHA GATEWAY
Hawai'i
P.O. BOX 5404 Kaneohe, Hawaii 96744
Tokyo
150-0001 Metroça 102, Jingumae, Shibuya, Tokyo
TEL 03-5467-3961 {alakagraphis}
Copyright 2020 pukalanibrand. All Rights Reserved.